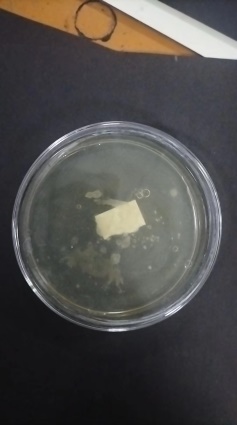

1. Introduction
The pattern of vegetation layer is grown and formed naturally during the preservation of the original earthen sites. It is a development form on the entire life cycle of earthen sites. The surface layer has unique functions of historical information, artistic aesthetics, soil fixation, and climate regulation. However, the fissures of earthen sites formed by the root splitting action of plants, abbreviated as root splitting fissures, increase the possibility of surface erosion, seriously hindering the large-scale use of vegetation restoration methods and urgently needing to be addressed.
The research on the restoration material of root splitting fissure is still in the blank stage. Here, we refer to relevant research on soil fissures for target screening. There are three types of fissure restoration materials. They are inorganic materials, organic materials and organic-inorganic composite materials. Among them, modified hydraulic lime (CaO) [1], hydrated lime (Ca(OH)2) [2], and Sporosarcina Pasteurii (abbreviated as Pasteurii)[3], have common advantages in restoring root splitting fissures, while Pasteurii has a more obvious advantage in restoring plant root fissures (Table 1).
Table 1. Statistical table of restoration results of materials.
Volume mean diameter | Product | Restoration location | Curing time | pH | |
CaO | Depending on ingredient list. | CaCO3 | Randomization | Long time | alkalinity |
Ca(OH)2 | >30μm | Randomization | Long time | >10 | |
Pasteurii | <10μm | To prioritize sealing surface fissures, to restore micron-fissures. | About 15 days if providing urea + Ca2+. | Survival interval= 6-13, reaction value ≈ 9.6. |
As a main driving factor of the geochemical cycles, Pasteurii belongs to a typical urease producing bacteria [2] of microbial induced carbonate precipitation (abbreviated as MICP, Figure 1). It is firstly extracted from soil [4] and later found in many places such as limestone [5]. It has the characteristics of being non-toxic, environmentally friendly, stable and not prone to aging. At this stage, the cementing performance [6-9] is widely studied and applied for patents [10].
|
Figure 1. Schematic figure of Pasteurii restoring root splitting fissures. |
Research has confirmed that Pasteurii [11] had a diameter of 0.5μm and a length of 2μm, meeting the standard of micron restoration for root splitting fissures. Pasteurii was an aerobic strain that prioritized sealing surface fissures. No matter how the pH value was adjusted in the early stage, the pH value the restored bacteria solution tended to be alkaline in a stable state, which was inhibit on root growth. This restoration method not only retained the advantages of soil reinforcement, thermal insulation, moisture retention, and flow resistance of plants themselves, but also met the requirements of minimizing intervention in root splitting fissures. It was an ideal method for root splitting fissures restoration. If this study can solve the problem of root fissures, its application value and market prospects are broad.
2. Research method
This study selected Pasteurii (DSM 33, Figure 2) as the target strain. It was produced by Leibniz Institute DSMZ in Germany. The solid medium was CASO AGAR (Merck 105458), which was used to resuscitate Pasteurii (Figure 3).
| Figure 2. Pasteurii preserved by vacuum drying. |
|
|
|
|
|
|
I27h | II27h | III27h | IV27h | V27h | VI27h |
|
|
|
|
|
|
I54h | II54h | III54h | IV54h | V54h | VI54h |
Figure 3. Resuscitated Pasteurii in solid medium. | |||||
2.1. Experimental area
Jinyang Ancient City has a long history (497-979 BC). It was an important political, economic, and military center in ancient China. The site is located next to the G5 Jingkun Expressway in Jinyuan District, southwest of Taiyuan City, Shanxi Province, China. It belongs to a semi-humid climate zone. The Western City Wall is a typical rammed earthen site. The plants are mainly composed of shrubs and herbs, and the root splitting fissures exist at the edge of the earthen sites. Research has confirmed that calcite accumulation was existed on the Western City Wall in Jinyang Ancient City. This study will provide reference for the study of vegetation layer in rammed earthen sites in the semi-humid climate zone in central and eastern China.
2.2. Experimental design
The main objective of this study is to provide high concentration and high-quality Pasteurii that can be used for restoring root splitting fissures. Based on the complex growth, reproduction, and metabolism of Pasteurii, which are influenced by numerous factors, this study mainly conducts single factor comparative experiments on culture media from three aspects: nutrients, culture conditions, and inoculation conditions. During the culture period of each experiment, multiple samples need to be taken at different times according to the experimental needs, and the values of temperature, pH, OD600, and conductivity should be tested separately. The residual Pasteurii solution the conical flasks should be preserved by original culture conditions.
2.2.1. Nutrients. To obtain better growth nutrients for Pasteurii, three mediums were prepared in 300mL. They were CASO AGAR (Merck 105458), LB medium, and ATCC medium 1376 NH4-YE medium. They were all placed in a conical flask, marked respectively as M1, M2, and M3. Before inoculation, the following three culture mediums need to be subjected to high-temperature sterilization treatment.
A small amount of Pasteurii bacteria were selected from solid culture medium using a sterilized inoculum and were placed in liquid culture medium for shaking culture. Taking Pasteurii solution cultured for different times with good growth as seed bacteria, the temperature of constant temperature oscillator was set to 30 ℃, the oscillation frequency was set to 170r/min, and the culture time was 24h.
2.2.2. Culture conditions. Research has confirmed that the target strain has the best dissolved oxygen (DO) effect when the oscillation frequency was in 170r/min [12]. The oscillation frequency was set to 170r/min. M1 medium was selected as liquid culture medium. Bacteria with good growth were selected as seed bacteria. And the culture time was 24h.
(a) pH
M1 medium was in 1500mL. In units of 90mL, the culture medium was divided into each conical flask. The pH of the culture medium was calibrated by hydrochloric acid or sodium hydroxide at a rate of 2μL each time. The liquid in the conical flask was replenished to 100mL at last. The temperature of constant temperature oscillator was set to 30 ℃.
(b) Temperature
Research has shown that the lower the culture temperature, the longer the growth delay period of Pasteurii. It took nearly 20h to enter the logarithmic growth phase under 20 ℃ conditions, the Pasteurii solution concentration did not reach its growth peak at 24h, and the growth rate was relatively slow [2]. Based on experimental data at 30 ℃ was obtained, five parameters were mainly measured here. They were 31 ℃, 32 ℃, 33 ℃, 34 ℃, and 37 ℃.
M1 medium was in 500mL. In units of 98mL, the culture medium was divided into each conical flask. In units of 2 mL (2%), the seed bacteria were inoculated into each conical flask. By adjusting the temperature of constant temperature oscillator, the effect of controlling culture medium temperature was achieved. The pH was set to 7.3.
2.2.3. Inoculation conditions. M1 medium was selected as liquid culture medium. The temperature of constant temperature oscillator was set to 30 ℃, and the oscillation frequency was set to 170r/min.
(a) Inoculation age
M1 medium was in 3500mL. Firstly, in units of 50mL, M1 culture medium was divided into 6 conical flasks. Bacteria in different inoculation ages with good growth were selected as seed bacteria. In units of 198mL, the culture medium was divided into each conical flask. In units of 2 mL, the seed bacteria were inoculated into each conical flask. The culture time was 24h.
(b) Inoculation amount
M1 medium was in 2000mL. In units of 50mL, the culture medium was divided into each conical flask. Bacteria with good growth were selected as seed bacteria. The seed bacteria were inoculated into each conical flask in different proportion. The liquid in the conical flask was replenished to 100mL at last. The culture time was based on different conditions.
2.3. Characterization parameters
The concentration of Pasteurii was measured by photoelectric turbidimetry at a wavelength of 600nm, using uninoculated culture medium as a blank control, characterized by optical density value (OD600), and measured using a UV-1800 ultraviolet spectrophotometer, as in Equation (1) [2].
\( X=3.283×D-0.053 \) (1)
where:
X is the absolute concentration of Pasteurii, in 108cell/mL;
D is the optical density OD value of bacteria solution measured at 600nm.
The urease activity of Pasteurii could be qualitatively determined by colorimetric methods, which was in traditional method [13-16]. However, its quantitative indicators could not be directly obtained. Research has shown that the amount of Pasteurii urease increased the ion concentration in the bacteria solution when decomposing urea, leading to an increase in the conductivity of the bacteria solution [11]. Urease activity could be characterized by measuring the growth rate of conductivity in bacteria solution. The measuring instrument of conductivity was multi-parameter measuring instrument, and the model was DZS-708L, as in Equation (2) [3].
\( UA=\frac{{σ_{1}}-{σ_{2}}}{t}×11.5249 \) (2)
where:
UA is urease activity, in m𝑆·(𝑐𝑚·𝑚𝑖𝑛)−1;
σ1 is the value of initial conductivity, σ2 is the value of conductivity after t minute, in m𝑆·𝑐𝑚−1.
3. Experimental results and discussion
3.1. Nutrients
3.1.1. Change rule in different media conditions. It was known that after being inoculated, Pasteurii would reproduce in a diploid manner, and the daughter cells after division had the ability to live. Bacteria that reproduce through the two division method generally followed the growth curve propagation pattern of four stages: delay period, logarithmic period, stable period, and decay period [17-18].
The growth curve distribution of Pasteurii followed the following pattern. After inoculation with M1 medium, the number of cells remained almost unchanged within 5h. After 5h, cell division increases logarithmically, reaching its peak at around 13h and gradually stabilizing, and the cells showed negative growth. After inoculation with M2 medium, the number of cells remained almost unchanged within 5h. After 5h, cell division increased logarithmically, reaching its peak at around 14h and gradually stabilizing, and the cells showed negative growth. After inoculation with M3 medium, the number of cells remained almost unchanged within 9h, but gradually increased after 9h, with the highest 24-hour value in existed data.
The summary of the reproduction pattern of Pasteurii was as follows. Pasteurii did not immediately reproduce after inoculation into the culture medium, and the number of cells remained almost unchanged for a certain period of time. The cell division was slow and in a delayed period. Subsequently, the cells of Pasteurii underwent a delay period adjustment and entered the rapid division stage. The number of newly formed Pasteurii increased geometrically, and the cell division rate reached its maximum. This stage was the logarithmic phase. Next, with the consumption of nutrients, harmful metabolites gradually accumulated, and the cell division rate decreased. The number of new cells was similar to dead ones, in a dynamic equilibrium state. The above stage was in a stable period. After that, the number of dead cells of Pasteurii increased sharply, the cells began to autolyze, the metabolites increased, the total viable bacteria count decreased, and a negative growth occurred. This stage was called decay period.
The distribution of urease activity in Pasteurii followed the following pattern. After inoculation with M1 medium, there was no significant change in urease activity within 5h. However, after 4h, urease activity increased rapidly and reached its peak around 10h. After 15h, urease activity gradually decreased. After inoculation with M2 medium, there was little change in urease activity within 5h. After 5h, urease activity increased rapidly and reached its peak around 14h. After 15h, urease activity gradually decreased. After inoculation with M3 medium, there was little change in urease activity within 11h. After 11h, urease activity increased rapidly and reached its peak range of 18-20h. After 20h, urease activity gradually decreased. It could be seen that the urease metabolism of Pasteurii in the logarithmic phase was most active.
By comparing the concentration and urease activity distribution of Pasteurii, it could be seen that the peak of growth curve of Pasteurii lagged slightly behind the peak of urease activity. Therefore, it was not recommended to choose pasteurized bacteria solution that was at the peak of urease activity for remediation. It was slightly shorter in time than the peak of growth curve.
3.1.2. Change rule in different inoculation ages. When we used M1 medium, the effect of different inoculation ages on concentration of bacteria solution showed a trend of 105h > 27h >79h >54h. When we used M2 medium, the effect of different inoculation ages on the concentration of bacteria solution showed a trend of 105h >27h >54h >79h. When we used M3 medium, the effect of different inoculation ages on the concentration of bacteria solution showed a trend of 105h >79h >54h >27h. It can be seen that after the inoculation age exceeds 100h, the delay period of the growth curve of Pasteurii was significantly shortened, and the peak concentration of the bacteria solution was significantly increased.
When we used M1 medium, the effect of different inoculation ages on the urease activity of bacteria solution showed a trend of 27h >79h >54h >105h. When we used M2 medium, the effect of different inoculation ages on the urease activity of bacteria solution showed a trend of 54h >27h >105h >79h. When we used M3 medium, the effect of different inoculation ages on the urease activity of bacteria solution showed a trend of 79h >105h >27h >54h. The urease activity of Pasteurii reached its peak at around 10-12h using M1 medium and seed bacteria culture time of 27h. The urease activity of Pasteurii reached its peak at around 6h after 105h, and the peak was significantly reduced. The urease activity of Pasteurii reached its peak at around 14h using M2 medium and seed bacteria culture time of 54h, while the urease activity of Pasteurii reached its peak at around 9h after 105h, and the peak was significantly reduced. The urease activity of Pasteurii reached its peak around 15-18h using M3 medium and seed bacteria culture time of 79h. The urease activity of Pasteurii reached its peak around 12-15h after 105h, and the peak value significantly increased. It can be seen that the older the inoculation age, the earlier the peak of urease activity of Pasteurii appeared, but the smaller the peak value.
By comprehensively comparing the bacteria concentration and urease activity performance of different culture media, it was recommended to choose an inoculation age of around 27h when using M1 culture medium. If using M2 medium, it was recommended to choose an inoculation age range of 27-54h. If using M3 medium, it was recommended to choose an inoculation age of over 54h. It was recommended to use M1 medium for the breeding of Pasteurii in this project, and the culture time of seed bacteria should not be too long.
3.2. Culture conditions
3.2.1. Change rule in different pH values. The initial value of the bacteria solution in this experiment was within the range of 5.5-10, and the pH value of the bacteria solution followed the following pattern over time. When the initial pH value of the bacteria solution was in the range of 7.25-9, the pH tended to approach 9 after about 5h and stabilized after 24h. When the initial pH value of the bacteria solution was 7, the pH tended to approach 9 around 6h and stabilized after 24h. When the initial pH values of the bacteria solution were 5.5 and 10, the pH tended to approach 9 after about 10h and stabilized after 24h. It can be seen that when the pH value was within the range of 5.5-10, it was within the overall tolerance range of the bacteria solution and tended to stabilize the pH value after a certain period of time. This conclusion shared the same trend as the thesis conclusion of Dr. Fan [12].
Preliminary inference suggested that the reasons for the above phenomenon were as follows. Pasteurii produced urease to hydrolyze the urease in the environment into NH4+ and CO32-. Based on the fact that the degree of hydrolysis of CO32- was greater than that of NH4+, it led to an increase in the concentration of hydroxide ions (OH-) in the solution, causing an increase in the environmental pH value, resulting in an alkaline solution.
3.2.2. Concentration change rule in different pH values. The concentration of bacteria solution followed the following pattern as pH changes. After inoculation, the target strain often had a delay period of time ty [2], during which the increase in cell concentration was not significant, and the bacteria solution ty values at pH 5.5 and 10 were significantly longer than that pH 7-9. When the pH value was within the range of 5.5-10, the growth curve of Pasteurii followed the development trend of delay period, logarithmic period, stable period, and decay period. That was, the bacteria liquid concentration first slowly increased, then rapidly increases, reached its peak around 24h, then rapidly decreased, and gradually tended to stabilize. It was known that pH mainly affected the growth and reproduction of microorganisms by affecting enzyme activity, substrate utilization rate, and cell structure. It can be seen that the pH value within the range of 5.5-10 is within the overall tolerance range of the bacteria solution.
In summary, the initial pH value of the culture medium that was too acidic or too alkaline would prolong the delay period time ty after inoculation of the target strain, but it had little effect on the growth curve distribution of Pasteurii. No matter how the pH changed, the growth curve distribution of Pasteurii was basically the same. When the seed fungus was a first generation bacterium and the culture time was 105h, the bacteria concentration reached its peak around 24h, and the peak value was 16.21 × 108 cells/mL when the pH was adjusted to 7.25. This indirectly verified the rationality of pH adjustment to 7.3 in M1 culture medium.
3.2.3. Change rule in different temperature. The growth curves and urease activity of Pasteurii in different temperature conditions (Figure 4) showed as follows. The distribution pattern of the growth curve of Pasteurii followed the pattern of 30 ℃>33 ℃>32 ℃>34 ℃>37 ℃. The distribution pattern of urease activity of Pasteurii followed 34 ℃>30 ℃>37 ℃. It can be concluded that due to the high temperature at 37 ℃, inhibiting the growth, reproduction, and metabolism of Pasteurii by affecting enzyme activity, cell membrane fluidity, and substance solubility could lead to premature entry into its stable and declining growth period. In summary, the bacteria concentration and urease activity were relatively good at 30 ℃, which was consistent with the thesis conclusion of Dr. Wei [11]. It is recommended to set the culture temperature to 30 ℃.
|
|
(a) Growth curves | (b) Urease activity |
Figure 4. Distributions of growth curves (upper) and urease activity (lower) of Pasteurii in different temperature conditions. | |
3.3. Inoculation conditions
3.3.1. Change rule in different inoculation ages. The growth curve of the third-generation bacteria in different inoculation ages followed the following pattern. The growth curve of Pasteurii followed the development trend of delay period, logarithmic period, stable period, and decay period. That was, the bacteria liquid concentration gradually increased, with a small peak around 48h, then rapidly decreased, and then gradually increased, reaching the second peak after 72h. When the inoculation age was in the range of 11-18h, the growth curve of Pasteurii with the inoculation age of 12-16h was better. When the inoculation age was in the range of 19-30h, the growth curve of Pasteurii with an inoculation age of 20h was better. Compared with the inoculation age range of 19-30h, the delay time of the growth curve of Pasteurii ty was slightly longer, and the bacteria concentration around 24h was slightly higher.
The urease activity of third-generation bacteria in different inoculation age conditions followed the following pattern. The urease activity of third-generation bacteria gradually increased and reached its peak around 60h, and then gradually decreased. When the inoculation age was in the range of 11-18h, the urease activity reached its highest at 60h after 16h of inoculation, but it decreased severely at 72h, so it was not recommended to use it. When the inoculation age was in the range of 19-30h, there was little change in urease activity. Compared with the inoculation age range of 19-30h, the urease activity at 24h in the former was slightly higher than that in the latter.
It can be seen that the growth curve and urease activity of Pasteurii with the inoculation age range of 11-18h were better than those with the inoculation age range of 19-30h. The reasons were as follows. When the inoculation age was older, the bacteria concentration continuously increased with the extension of culture time. However, with the consumption of medium and the accumulation of metabolite, the bacteria concentration no longer increased and tended to aging. This aging seed would cause a decrease in production capacity and premature cell autolysis. At this time, the quality of seed collection showed a downward trend, leading to poor urease activity in the bacteria solution.
Based on a comprehensive assessment of bacteria concentration and urease activity (Table 2), it was recommended to select inoculation age range of 12-13h. This conclusion was consistent with the thesis conclusion of Dr. Wang [2].
Table 2. Parameters of concentration and urease activity of Pasteurii in different inoculation ages.
time | Inoculation age | ||||||||||||||||
11h | 12h | 13h | 14h | 15h | 16h | 17h | 18h | ||||||||||
X | UA | X | UA | X | UA | X | UA | X | UA | X | UA | X | UA | X | UA | ||
23h | 6.29 | 0.93 | 7.49 | 0.8 | 6.49 | 0.71 | 7.66 | 0.65 | 5.24 | 0.98 | 5.8 | 1.21 | 6.44 | 1.28 | 7.26 | 0.94 | |
48h | 5.22 | 0.66 | 8.28 | 0.86 | 8.61 | 0.98 | 6.46 | 0.76 | 6.07 | 1.25 | 6.01 | 1.53 | 7.51 | 0.86 | 7.04 | 0.86 | |
60h | 5.9 | 1.25 | 5.95 | 1.59 | 6.32 | 1.5 | 6.68 | 1.3 | 5.79 | — | 6.44 | 1.74 | 6.15 | 1.2 | 5.9 | 1.36 | |
72h | 7.98 | 1.04 | 9.65 | 1.11 | 7.23 | 1.61 | 7.93 | 0.66 | 7.27 | 0.6 | 7.69 | 0.57 | 6.86 | 0.58 | 7.37 | 0.59 | |
time | Inoculation age | ||||||||||||||||
19h | 20h | 22h | 24h | 25h | 27h | 28h | 30h | ||||||||||
X | UA | X | UA | X | UA | X | UA | X | UA | X | UA | X | UA | X | UA | ||
17h | 4.9 | 0.58 | 5.2 | 0.55 | 4.99 | 0.54 | 5.02 | 0.7 | 5.05 | 0.6 | 4.4 | — | 4.6 | 0.55 | 3.26 | 0.49 | |
18h | 4.98 | 0.59 | 5.15 | 0.45 | 5.24 | 0.6 | 4.63 | 0.68 | 5.11 | 0.59 | 4.81 | — | 4.11 | 0.49 | — | — | |
19h | 5.12 | 0.58 | 5.98 | 0.49 | 4.71 | 0.68 | 5.05 | 0.61 | 4.42 | 0.49 | 4.11 | — | 4.45 | 0.52 | — | — | |
20h | 5.54 | 0.66 | 6.27 | 0.61 | 4.2 | 0.52 | 4.6 | 0.51 | 5.22 | 0.71 | 4.23 | — | — | — | — | — | |
21h | 5.44 | 0.67 | 5.58 | 0.68 | 5 | 0.53 | 5.01 | 0.56 | 4.7 | 0.59 | — | — | — | — | — | — | |
22h | 5.58 | 0.75 | 5.12 | 0.5 | 4.6 | 0.51 | 4.88 | 0.55 | 4.92 | 0.66 | — | — | — | — | — | — | |
23h | 5.33 | 0.7 | 5.75 | 0.66 | 5.06 | 0.7 | 5 | 0.56 | — | — | — | — | — | — | — | — | |
24h | 5.35 | 0.58 | 5.55 | 0.55 | 5.1 | 0.63 | — | — | — | — | — | — | — | — | — | — | |
3.3.2. Change rule in different inoculation amount. The growth curve of Pasteurii in different inoculation amounts followed the following pattern. The concentration of bacteria solution gradually increased. When the inoculation amount was in the range of 0.5%-4%, the growth curve of Pasteurii with an inoculation amount of 3% was best. When the inoculation amount was in the range of 9%-16%, the growth curve of Pasteurii with an inoculation amount of 12% was best. Compared with the inoculation amount in the range of 0.5%-4% and the inoculation amount in the range of 9% -16%, the former had a slightly higher bacteria concentration after about 24h.
The urease activity of Pasteurii in different inoculation amount followed the following pattern. When the inoculation amount was in the range of 0.5%-4%, there was not much difference in the urease activity of Pasteurii, following the rule of a slow growth and stable change pattern after 8h. When the inoculation amount was in the range of 9%-16%, there was not much difference in the urease activity of Pasteurii, following the rule of rapid growth within 2h, slow growth after 2h, peak at around 8-10h, stabilization and gradual decreased after 10h, and slow growth after 20h. Compared with the inoculation amount in the range of 0.5%-4% and inoculation amount in the range of9%-16%, the former was slightly lower than the one of the latter.
It can be seen that when the inoculation amount was low, it was conducive to the growth curve distribution of Pasteurii. When the inoculation amount was high, the urease activity of the bacteria solution could quickly reach the requirements. Based on a comprehensive assessment of the bacteria concentration and urease activity (Table 3), it was recommended to select the inoculation amount of 3%.
Table 3. Parameters of concentration and urease activity of Pasteurii in different inoculation amount.
time | Inoculation amount | |||||||||||||||
0.5% | 1% | 1.5% | 2% | 2.5% | 3% | 3.5% | 4% | |||||||||
X | UA | X | UA | X | UA | X | UA | X | UA | X | UA | X | UA | X | UA | |
24h | 6.45 | 0.86 | 8.45 | 0.9 | 8.16 | 0.98 | 7.53 | 0.41 | 8.16 | 0.46 | 9.07 | 0.9 | 9.04 | 0.43 | 8.74 | 0.9 |
time | Inoculation amount | |||||||||||||||
9% | 10% | 11% | 12% | 13% | 14% | 15% | 16% | |||||||||
X | UA | X | UA | X | UA | X | UA | X | UA | X | UA | X | UA | X | UA | |
24h | 5.26 | 0.78 | 5.62 | 0.77 | 5.16 | 0.8 | 6.08 | 0.93 | 4.64 | 0.75 | 5.13 | 0.86 | 4.87 | 0.77 | 5.31 | 0.97 |
4. Conclusion
This study explored the adaptability of MICP technology for restoring root splitting fissures of plants, and used single factor comparative experimental method to study the characteristics of growth curves and urease activity of Pasteurii in different conditions in earthen sites of Jinyang Ancient City. The aim was to provide suitable breeding conditions for Sporosarcina Pasteurii.
(a) The technology of MICP was well suited for restoring root splitting fissures of plants. The technology of MICP could meet the requirements of restoring earthen sites by sealing surface fissures and inhibiting root growth of plants. Moreover, the physical morphology of damaged plant roots and stems could still be preserved, which was conducive to improving the soil's resistance to erosion and weathering. It was an ideal method for restoring root splitting fissures of plants.
(b) It was recommended to use the medium of M1. No matter how the conditions change, the growth curve of Pasteurii followed the follow four stages: delay period, logarithmic period, stable period, and decay period. When we used M1 medium, it was recommended to choose the inoculation age of 27h. When we used M2 medium, it was recommended to choose the inoculation age range of 27-54h. When we used M3 medium, it is recommended to choose the inoculation age of over 54h. When we used M1 medium, the time of bacteria solution in delay period was short, the concentration in stable period was high, the overall growth curve distribution was the best, and the urease activity value was the highest.
(c) The suggestion was to select Pasteurii as restoration solution when the urease activity was at peak period. It was slightly shorter than the peak time of the growth curve in terms of time.
(d) The medium of M1 was suggested to set the pH value to 7.25. Pasteurii produced urease to hydrolyze urea into NH4+and CO32-, simultaneously increasing the pH value of the environment and making the solution alkaline. When the pH value was within the range of 5.5-10, it was within the overall tolerance range of the bacteria solution and tended to stabilize after a certain period of time. The initial pH value of the culture medium that was too acidic or too alkaline would prolong the delay time ty after inoculation of Pasteurii, but it had little effect on the growth curve distribution. No matter how the pH changed, the growth curve distributions of Pasteurii had a similar trend. When the seed bacteria was the first generation bacteria and the culture time was 105h and the pH was adjusted to 7.25, the bacteria concentration reached its peak around 24h, and the peak value was 16.21 ×108cell/mL. It indirectly verified the rationality of pH adjustment to 7.3 in M1 culture medium.
(e) It was recommended to set the culture temperature to 30 ℃. The growth curves distribution of Pasteurii followed 30 ℃>33 ℃>32 ℃>34 ℃>37 ℃, and the urease activity distribution followed 34 ℃>30 ℃>37 ℃. The bacteria solution concentration and urease activity at 30 ℃ were best.
(f) The recommended inoculation age range was 12-13h. The growth curves and urease activity of Pasteurii with the inoculation age range of 11-18h were better than those with the inoculation age range of 19-30h.
(g) It was recommended to choose inoculation amount of 3%. When the inoculation amount was low, it was beneficial for the growth curve distribution of Pasteurii. When the inoculation amount was high, the urease activity of the bacteria solution could quickly reach the requirements.
5. Acknowledgements
This work was supported by [Shanxi Provincial Basic Research Program of China and Shanxi Provincial Cultural Relics Technology Program of China] under Grant [202303021212060 and 2023KT15].
References
[1]. Liu X B, Meng H, Wang Y L, Katayama Y and Gu J D 2018. Water is a critical factor in evaluating and assessing microbial colonization and destruction of Angkor sandstone monuments J. Int. Biodeterior. Biodegrad., 133,9-16.
[2]. Wang R X 2009. Study on biomineralization process of calcium carbonate mediated by microbe and its application in restoration of cement-based materials defects
[3]. Whiftin, V S, vail Paassert L and Harkes M P 2007. Microbial carbonate precipitation as a soil improvement technique J. Geomicrobiol. J., 24,417-23.
[4]. Boquet'E,Boronat A and Ramos-Cormenzana A 1973.Production of calcite(calcium carbonate) crystals by soil bacteria is ageneral phenomenon J.Nature,246(5434),527-9.
[5]. Adolphe J P and Billy C 1974. Biosynth6se de calcite par line association bact6rienne a&obieJ. C. R. Acad., 278, 2873-75.
[6]. Adolphe J P , Hourimeche A,Loubiere J, Paradas J and Soleilhavoup F 1989. Les formations carbonatees d'origine bacterienne; formations continentales d'Afrique du Nord,BSGF-EARTH SCI B,55-62
[7]. Castanier S G,Le Metayer-Levrel and Perthuisot J P 1999.Ca-carbonates precipitation and limestone genesis-the microbiolgeologist point of view J.Sediment. Geol.,126,9-23
[8]. Wu S F,Zhang Y,Su M,He D P,Li J and Feng H Y 2022.Advancement of biotechnology for the conservation and restoration of cultural heritage objects,Sciences of Conservation and Archaeology,1,133-43
[9]. Liu X B, Meng H, Wang Y L, Katayama Y and Gu J D 2018. Water is a critical factor in evaluating and assessing microbial colonization and destruction of Angkor sandstone monuments J. Int. Biodeterior. Biodegrad., 133,9-16.
[10]. Adolphe J P,Loubiere J F,Paradas J and Soleilhavoup F 1990.Procédé de traitement biologique d'une surface artificielle P.European patent 90400G97
[11]. Wei H 2023.Experimental study and mechanism analysis of microbial mineralization in repairing high-temperature concrete damage
[12]. Fan Y N 2022.Study on mechanism and multi-scale performance of biomineralization for repairing fire damage of concrete
[13]. Xu Y B,Qian C X and Lu Z W 2013.Study on enhancing urease thermostability of Bacillus pasteurii by glycerol J.Journal of Southeast University (Natural Science Edition),43(1),147-51
[14]. Qian C X, Wang J Y, Wang R X and Cheng L 2009.Corrosion protection of cement-based building materials by surface deposition of CaCO3 by Bacillus pasteurii,Materials Science and Engineering: C,29(4),1273-80
[15]. Sun X H 2019. Study on mechanism of microbial mineralization and application of it to repair concrete cracks
[16]. Wei H, Fan Y, Sun L, Du H and Liang R 2022. Experimental Study on High-Temperature Damage Repair of Concrete by Soybean Urease Induced Carbonate Precipitation J. Materials, 15(7):,2436.
[17]. Xiao L 2004 Experimental techniques for environmental microorganisms (Beijing:China Environmental Science Press)
[18]. Shen P 2006 Microbiology (Beijing: Higher Education Press)
Cite this article
Shang,R.;Du,X.;Han,P.;Liu,W. (2024). Culture optimization and regulation mechanism of sporosarcina pasteurii for restoring root splitting fissures in Jinyang ancient city. Advances in Engineering Innovation,5,33-43.
Data availability
The datasets used and/or analyzed during the current study will be available from the authors upon reasonable request.
Disclaimer/Publisher's Note
The statements, opinions and data contained in all publications are solely those of the individual author(s) and contributor(s) and not of EWA Publishing and/or the editor(s). EWA Publishing and/or the editor(s) disclaim responsibility for any injury to people or property resulting from any ideas, methods, instructions or products referred to in the content.
About volume
Journal:Advances in Engineering Innovation
© 2024 by the author(s). Licensee EWA Publishing, Oxford, UK. This article is an open access article distributed under the terms and
conditions of the Creative Commons Attribution (CC BY) license. Authors who
publish this series agree to the following terms:
1. Authors retain copyright and grant the series right of first publication with the work simultaneously licensed under a Creative Commons
Attribution License that allows others to share the work with an acknowledgment of the work's authorship and initial publication in this
series.
2. Authors are able to enter into separate, additional contractual arrangements for the non-exclusive distribution of the series's published
version of the work (e.g., post it to an institutional repository or publish it in a book), with an acknowledgment of its initial
publication in this series.
3. Authors are permitted and encouraged to post their work online (e.g., in institutional repositories or on their website) prior to and
during the submission process, as it can lead to productive exchanges, as well as earlier and greater citation of published work (See
Open access policy for details).
References
[1]. Liu X B, Meng H, Wang Y L, Katayama Y and Gu J D 2018. Water is a critical factor in evaluating and assessing microbial colonization and destruction of Angkor sandstone monuments J. Int. Biodeterior. Biodegrad., 133,9-16.
[2]. Wang R X 2009. Study on biomineralization process of calcium carbonate mediated by microbe and its application in restoration of cement-based materials defects
[3]. Whiftin, V S, vail Paassert L and Harkes M P 2007. Microbial carbonate precipitation as a soil improvement technique J. Geomicrobiol. J., 24,417-23.
[4]. Boquet'E,Boronat A and Ramos-Cormenzana A 1973.Production of calcite(calcium carbonate) crystals by soil bacteria is ageneral phenomenon J.Nature,246(5434),527-9.
[5]. Adolphe J P and Billy C 1974. Biosynth6se de calcite par line association bact6rienne a&obieJ. C. R. Acad., 278, 2873-75.
[6]. Adolphe J P , Hourimeche A,Loubiere J, Paradas J and Soleilhavoup F 1989. Les formations carbonatees d'origine bacterienne; formations continentales d'Afrique du Nord,BSGF-EARTH SCI B,55-62
[7]. Castanier S G,Le Metayer-Levrel and Perthuisot J P 1999.Ca-carbonates precipitation and limestone genesis-the microbiolgeologist point of view J.Sediment. Geol.,126,9-23
[8]. Wu S F,Zhang Y,Su M,He D P,Li J and Feng H Y 2022.Advancement of biotechnology for the conservation and restoration of cultural heritage objects,Sciences of Conservation and Archaeology,1,133-43
[9]. Liu X B, Meng H, Wang Y L, Katayama Y and Gu J D 2018. Water is a critical factor in evaluating and assessing microbial colonization and destruction of Angkor sandstone monuments J. Int. Biodeterior. Biodegrad., 133,9-16.
[10]. Adolphe J P,Loubiere J F,Paradas J and Soleilhavoup F 1990.Procédé de traitement biologique d'une surface artificielle P.European patent 90400G97
[11]. Wei H 2023.Experimental study and mechanism analysis of microbial mineralization in repairing high-temperature concrete damage
[12]. Fan Y N 2022.Study on mechanism and multi-scale performance of biomineralization for repairing fire damage of concrete
[13]. Xu Y B,Qian C X and Lu Z W 2013.Study on enhancing urease thermostability of Bacillus pasteurii by glycerol J.Journal of Southeast University (Natural Science Edition),43(1),147-51
[14]. Qian C X, Wang J Y, Wang R X and Cheng L 2009.Corrosion protection of cement-based building materials by surface deposition of CaCO3 by Bacillus pasteurii,Materials Science and Engineering: C,29(4),1273-80
[15]. Sun X H 2019. Study on mechanism of microbial mineralization and application of it to repair concrete cracks
[16]. Wei H, Fan Y, Sun L, Du H and Liang R 2022. Experimental Study on High-Temperature Damage Repair of Concrete by Soybean Urease Induced Carbonate Precipitation J. Materials, 15(7):,2436.
[17]. Xiao L 2004 Experimental techniques for environmental microorganisms (Beijing:China Environmental Science Press)
[18]. Shen P 2006 Microbiology (Beijing: Higher Education Press)